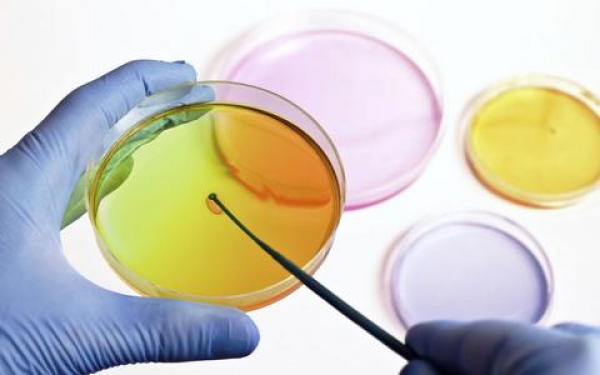

Φάρμακο για ανοσία στη γρίπη
25 Απριλίου 2014
Το σκεύασμα μπλοκάρει τη δράση του μορίου PGE2 (προσταγλαδίνη Ε2) Και βοήθησε να επιβιώσουν ποντίκια στα οποία χορηγήθηκε ιός της γρίπης των χοίρων.
Οι ειδικοί εμφανίζονται αισιόδοξοι ότι το φάρμακο θα μπορέσει να έχει το ίδιο αποτέλεσμα και στον ανθρώπινο οργανισμό, προφυλάσσοντας και αποσοβώντας έτσι χιλιάδες θανάτους ετησίως που οφείλονται στην εμφάνιση όλο και πιο ισχυρών στελεχών του ιού της γρίπης.
Πηγή: onlycy.com